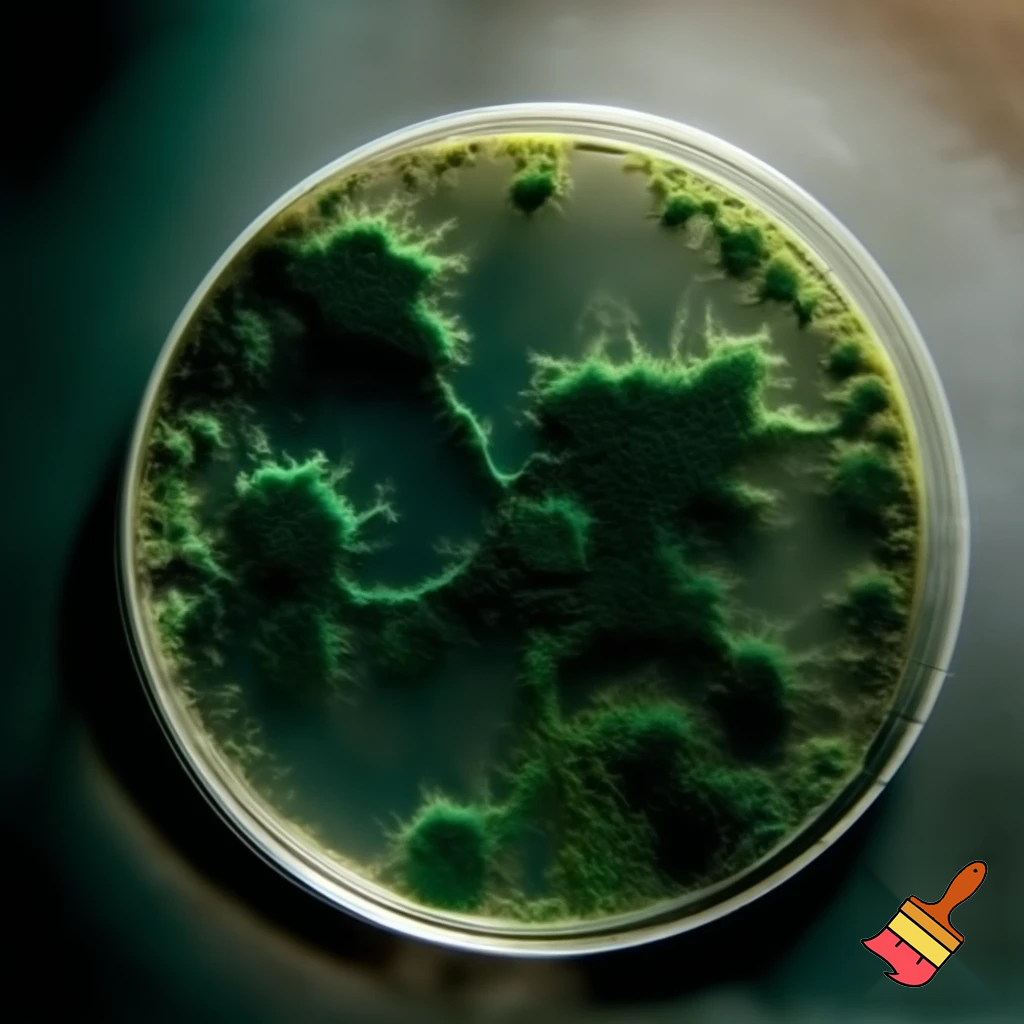
dark green mold on a petri dish

-
What is Craion AI?

Imagine having your own personal genie to draw anything that comes to mind, whether you’re a complete beginner or experienced artist. With Craion AI, there’s no need to imagine!
Previously known as DALL·E mini, Craion AI is the new kid on the tech block and the best AI art generator (in our community’s words!). The brainchild of our CEO, lead researcher, and AI hero, Boris Dayma, Craion AI is a free AI image generator that’s painting a new generation for the AI art revolution through our own model. Since 2022 (has it really been a year already…?) we’ve been ushering in the next era of AI image generation.
If you can dream it, Craion AI can draw it. Thanks to our advanced in-house-developed tech, a simple text prompt is all Craion AI needs to turn your imagination into AI reality – in seconds.
But this genie gives more than 3 wishes. Get 9 free images a month or go pro for unlimited art, fewer ads, and faster generation. Let your imagination run wild!
Sushi painted by van gogh? Your wish is our command. Gandhi as a Dragon Ball Z battle card? Granted.
Anything goes with Craion AI in your AI art tool box, from abstract art, aesthetic wallpapers, to breathtaking AI landscapes. Explore infinite possibilities for styles, themes, and techniques, and most importantly, have FUN exploring the boundless possibilities of AI generated images with us!
We’re constantly improving and updating our state-of-the-art technology to improve your Craion AI experience on the daily. We can’t wait to have you on-board to ride the AI wave with us.
-
How do I create images with Craion AI?

If you can type, you can use Craion AI to turn text into AI artwork!🥳
- Open Craion AI Art Generator
- Type your idea (crazy concepts encouraged)
- Hit “DRAW” to generate your AI art!
- Edit your AI image text prompt. With millions of art styles and photorealistic designs you can add, there are endless changes.
- Save or download your AI art masterpiece to share with the world!
Generating free AI art truly is as easy as typing in a prompt and letting Craion AI do the rest.
Need help with writing the best prompts for AI art generators?
We’ve got a blog for that! -
Will Craion AI’s text to image always be free?

We hope so. Paying members also help us continue researching text to image model technology, generative, developing, and building new models to ensure your Craion AI experience only gets better and better. For our free AI art creators, ads help pay for our (incredibly expensive) models behind the scenes.
-
Can you make images of higher quality?

Yes, we are constantly working on improving image quality. Make sure to use the "Upscale" option when there is an image you like to get a higher resolution. You can always try to do it multiple times but it should not affect much the result and will remain at the same resolution.
-
Negative words? What are those?

Is there anything you definitely DON’T want to see in your AI generated art? Like an awkward hat on your drawing of Mozart painted by Van Gogh? No problem. In the “Negative Word” section, simply type out concepts you’d like Craion AI to avoid, like “hat”, or “crocs”. 😆
You can also influence color, light of your AI images by adding the words you do not want to the negative words.
-
How does prompt prediction work?

Craion AI and ChatGPT work in cahoots to bring you the best AI drawing prompts this side of the web.
-
What do I do if I get the message "too much traffic?"

If you’re struggling to generate AI art with Craion AI, fear not!
Try pressing the draw button again. You may need to try a few times to generate ai images.
Depending on traffic, we’re increasing our server count as quickly as we can so everyone can generate their images.
-
Are you related to DALL·E mini?

Yes,
Boris Dayma who trained the current version of the AI model,
Pedro Cuenca who worked on the backend, and
Suraj Patil are part of the Craion AI team.
-
What if my images don’t appear?

We recommend trying a different browser first, or going incognito. Clearing your cache might also do the trick. If not, try restarting your phone or computer, or wait until a little later and try again.
After restarting your device and the AI generated images still don't appear, let us know through an email at
[email protected] or let us a message on
Discord and we'll look into it.
-
How does the AI model work?

The model learns concepts from images. Each time you enter a prompt, it will create unique images based on its current knowledge and will try to combine the concepts from your prompt in a creative way. You can find more details of an earlier model in
W&B Project Report and the
DALL·E mini model card.
-
Are there biases or limitations in AI generated art?

By nature, AI isn’t bias. However, seeing as it learns through humans, it could be exposed to societal prejudices and harmful stereotypes and integrate these into its images. Limitations and bias in AI are still being researched and are yet to be fully documented, which you can learn more about in the DALL-E mini model car
-
Can I use the images generated through Craion AI?

Yes, as long as you respect the Terms of Use, feel free to use them as you wish for personal, academic or commercial use!
Please credit craionai.com for the images if you are a free subscriber.
-
Is there a Craion AI app?

No we do not.
⚠️ WARNING: If you find a Craion AI AI drawing generator app on Google Play or the App Store, it’s not us! There are more copycats out there than we can count, but the real Craion AI doesn’t have an app just yet. If we do, you’ll be the first to know!
-
Craion AI rocks! How can I show my support?

It does, doesn’t it? Your feedback is gold to us. From bugs to feature requests, we’re all ears, always.
Loving Craion AI? Get more from the AI picture generator by upgrading to a paid plan.
You can also Get Some Swag by turning your favorite AI creations into a t-shirt, or support us with a donation if you’re feeling generous!
Your support means we can keep making our AI model better for you every single day, while making sure our free plan stays, well, free.